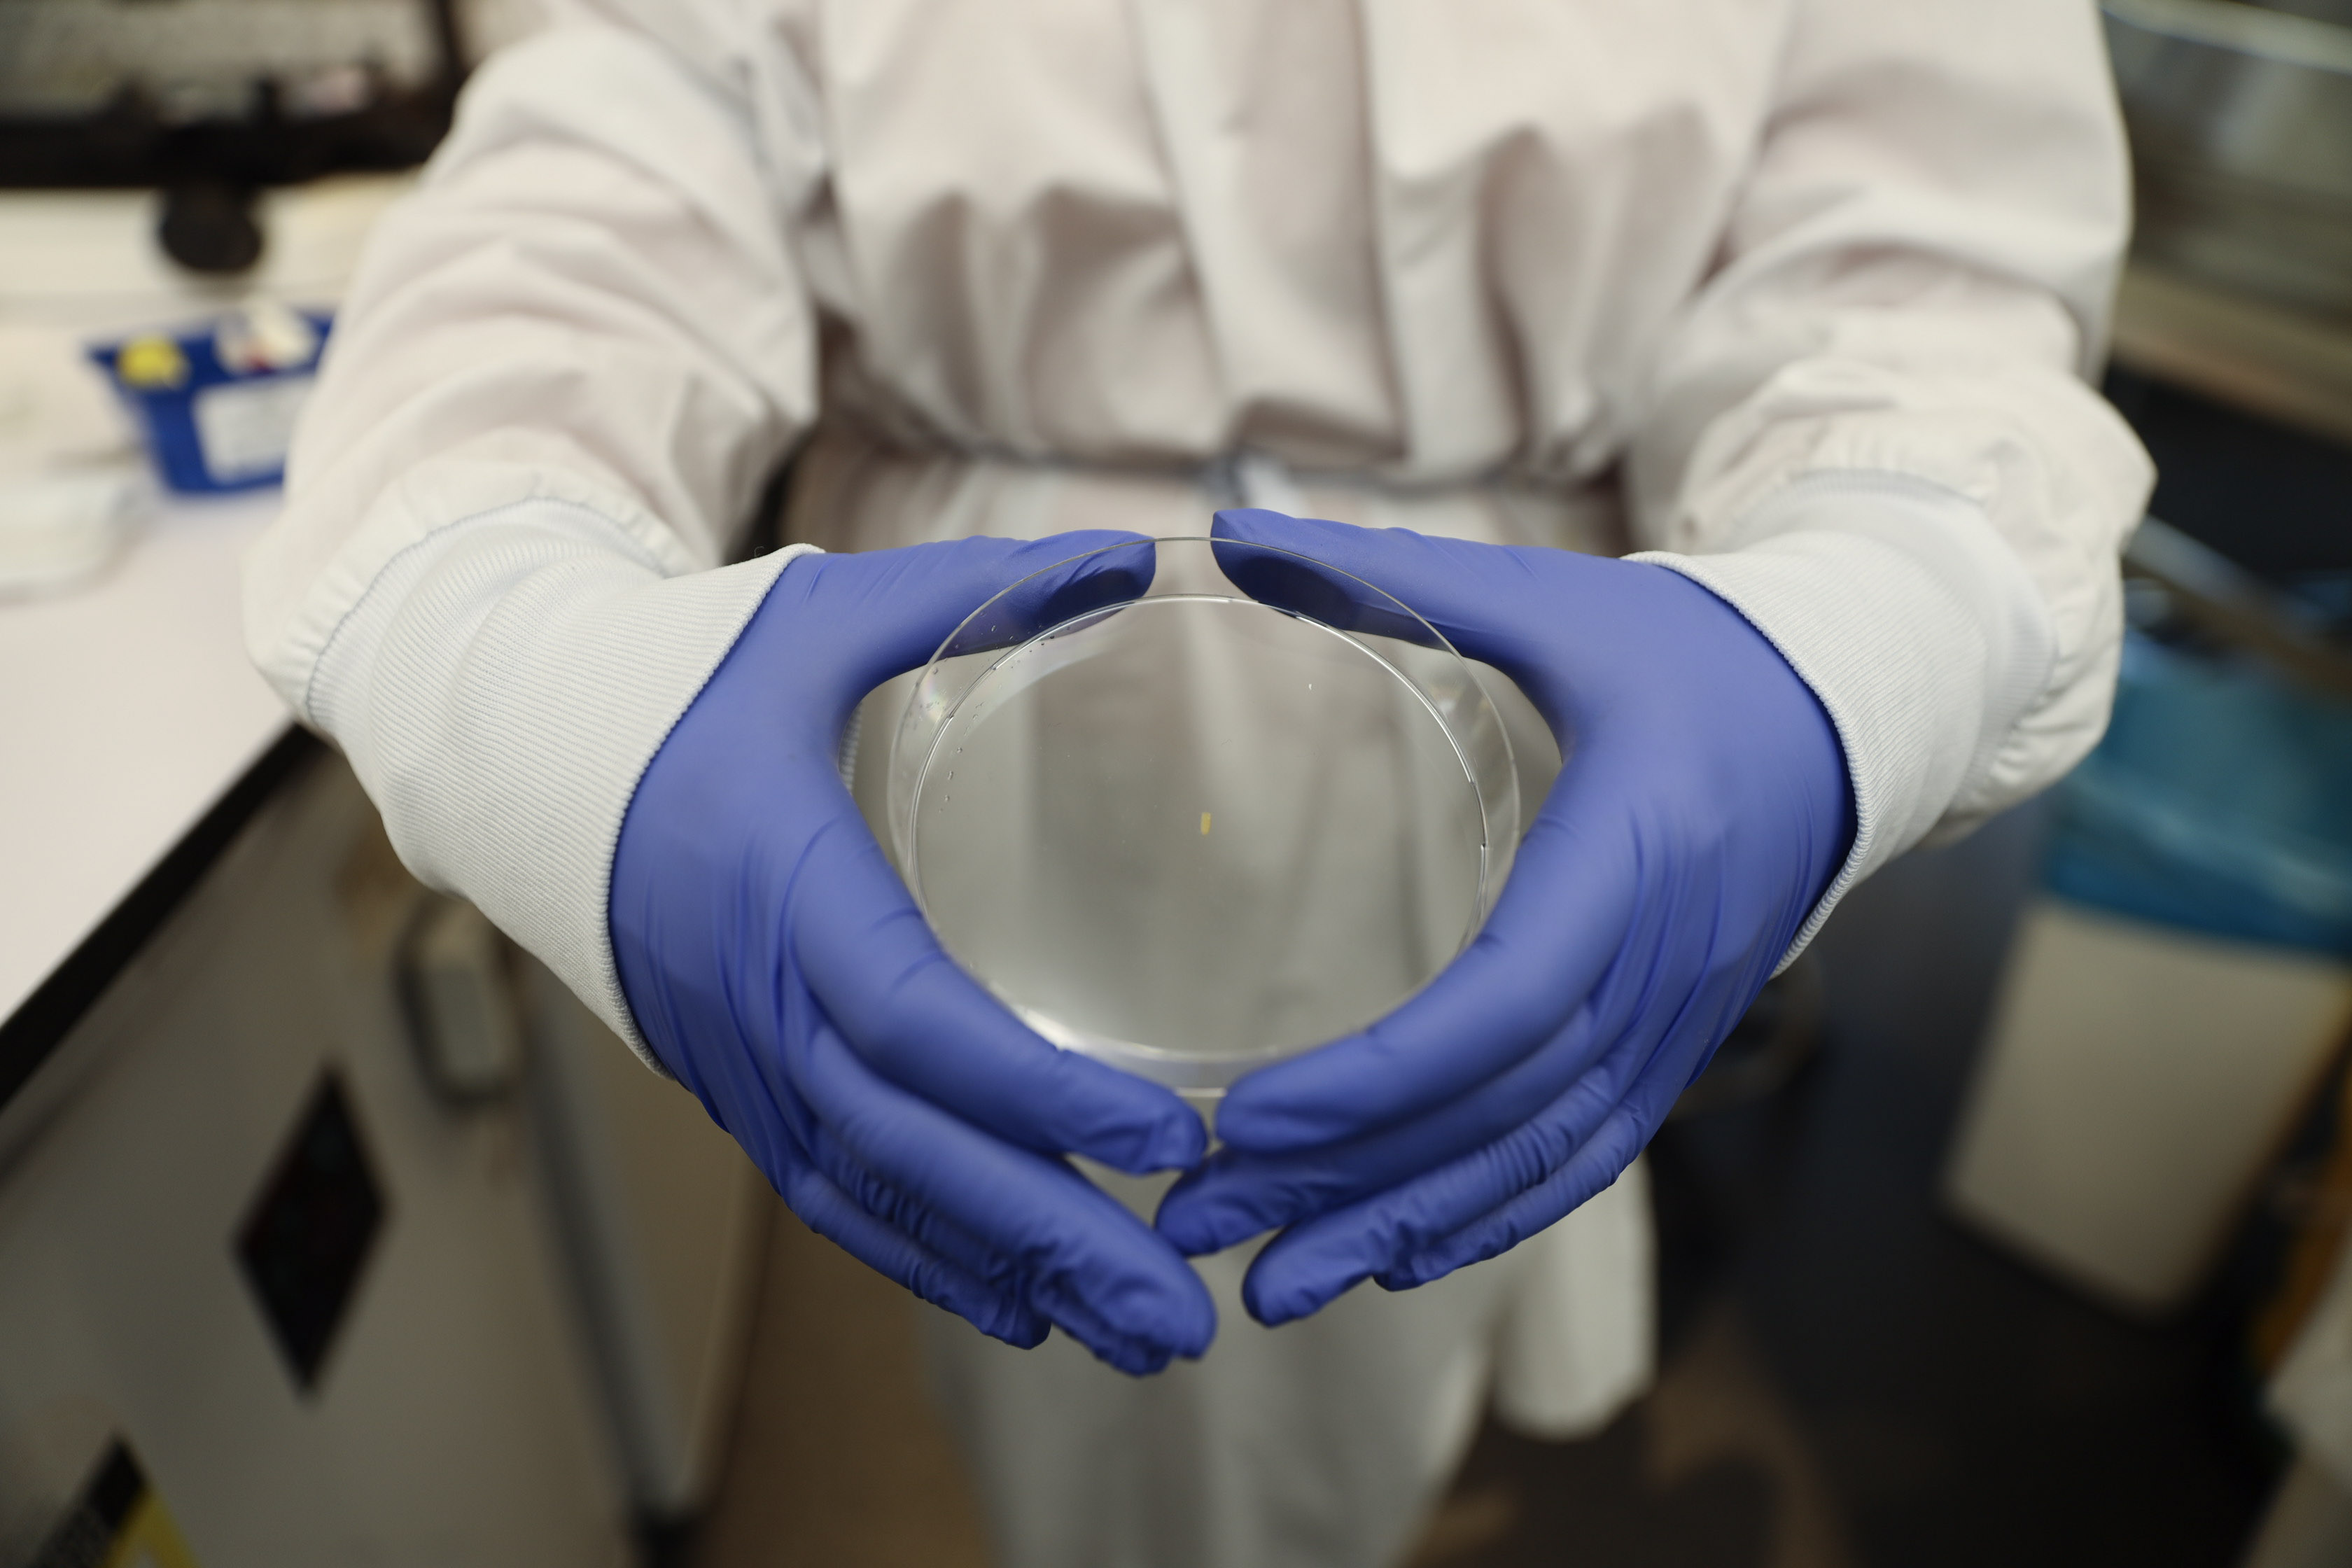

Swinburne-led research aims to improve health outcomes for pancreatic cancer patients
A prototype of the implant, which was developed at ACMD.
In summary
- A Swinburne-led research team is exploring the use of a tiny implant device that delivers chemotherapy directly into the tumour of a patient with pancreatic cancer.
- This technique could lead to improved surgical outcomes for patients with pancreatic cancer.
- The implant is part of a world-first project being developed by researchers from Swinburne and the University of Wollongong in partnership with ACMD, a collaborative, hospital-based biomedical engineering research centre.
A Swinburne-led research team is exploring the use of a tiny implant that delivers chemotherapy directly into the tumour of a patient with pancreatic cancer. This device could hold the key to improving surgical outcomes for patients by shrinking the tumour so it can be safely removed.
The proposed implant is part of a world-first project being developed by researchers from Swinburne and the University of Wollongong, in partnership with the Aikenhead Centre for Medical Discovery (ACMD) – Australia’s first collaborative, hospital-based biomedical engineering research centre located at St Vincent’s Hospital in Melbourne.

This tiny device, which is no bigger than a grain of rice has the potential to improve surgical outcomes for pancreatic cancer patients.
Revolutionising how pancreatic tumours are treated
‘This technique has the potential to transform the way pancreatic cancer is treated,’ says Swinburne Professor of Biomedical Electromaterials Science and ACMD Project Lead, Simon Moulton.
The implant will be loaded with the required doses of chemotherapy and inserted directly into the tumour through a minimally invasive endoscopic ultrasound. Once inserted, the medication will slowly leach out to shrink the tumour. The amount of chemotherapy needed will be determined by the size of the tumour, along with other factors specific to the patient.
The challenges of treating pancreatic tumours
According to the Australian Institute of Health and Welfare, pancreatic cancer is tipped to be the second leading cause of cancer deaths worldwide by 2030. It also has one of the lowest survival rates. In 2021, the five-year survival rate for a person diagnosed with the disease was just 10 per cent.
Treating pancreatic tumours is challenging for a number of reasons.
‘The size of some pancreatic tumours prohibits any surgical removal because the tumour may be encroaching to other parts of the body, which makes surgery risky,’ explains Professor Moulton.
Pancreatic tumours also have a dense, fibrotic layer that makes it difficult for traditional chemotherapy techniques to penetrate.
‘Another challenge is pancreatic tumours don’t have many blood vessels, which means it's hard to get high doses of the cancer-treating drug directly to the tumour, and when a whole-body dose is provided through an IV, you don’t actually know what percentage of that drug is getting to the tumour,’ says Swinburne research fellow Dr Lilith Caballero Aguilar, who is also involved in the project.
Dr Caballero specialises in the Drug Delivery field, specifically, designing novel biomaterials for drug delivery systems.
‘Using the proposed implant will overcome the problem of getting the drug to the tumour, not to mention, this site-specific approach could help eliminate some of the side effects patients experience when taking chemotherapy drugs,’ she adds.
Trialling the implants
First generation implants developed at the University of Wollongong and ACMD are showing promising results. The Swinburne implants will be evaluated at the University of Wollongong in suitable pancreatic cell culture models starting in September.
‘This technique would enable us to remove pancreatic cancer tumours from patients where previously this may not have been possible - and potentially improve survival rates,’ Professor Moulton concludes.
-
Media Enquiries
Related articles
-

- Design
- Technology
- Health
- Science
Award-winning interactive tool helps patients better understand inherited cancer risk
Swinburne, in partnership with the Peter MacCallum Cancer Centre and the University of Melbourne have developed The Cancer Risk Thermometer, an interactive decision support tool
Friday 12 June 2026 -

- Engineering
- Student News
Award-winning engineering student solution to benefit remote village
Swinburne engineering students’ waste-to-resource solution has been implemented in a Timor-Leste village.
Monday 15 June 2026 -

- Social Affairs
- Science
- Sustainability
- Engineering
Swinburne secures ARC Linkage funding for industry-focused research
Swinburne is the lead organisation for two ARC Linkage Projects while also contributing to four externally led projects
Thursday 28 May 2026 -

- Social Affairs
- Health
- University
Australian-first pilot targets ‘fixated grievance’ linked to family violence homicide and terrorism
The Fixated Grievance Perpetrator Intervention Pilot will bring together leading experts in forensic psychology and psychiatry, criminology, policing, courts, victim support and perpetrator intervention.
Monday 25 May 2026 -

- University
- Aviation
- Engineering
Swinburne appoints Dr Patryk Burka as AIR Hub Director
Dr Patryk Burka has been appointed as Director of Swinburne’s Aerostructures Innovation Research Hub (AIR Hub)
Monday 04 May 2026

